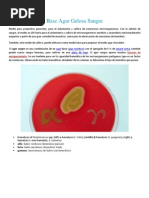
Download Base Agar Gelosa Sangre by deessire SN97259412 doc pdf

- Aneka Resep Pempek Palembang by inthr4_hk SN:9518965
- Resep Mudah Membuat Es Krim by 035m4n SN:22135299
- Bahasa Resep, Penulisan Resep Kuliah by Gesty Zenerra SN:40563741
- AsianCounsel_v8i9 by Simon Agar SN:46852309
- Resep Kue Semprit Coklat Masakan Khas Indonesia by fox djieto SN:12449077
- Resep Masakan by Putrimales SN:7626129
- agar agar by Wati Suin Suin SN:68441603
- Rapport Omar Agar by Omar Agar SN:178412241
- Materiales cerámicos y polimeros by Rai Jass Agar SN:91870231
- TCL Training Verdi 201107 by Rikki Agar SN:146591992
- 5 Resep Agar Agar - N. Zubaidi by Nanang Zubaidi SN:201113227
- node.js No de Beginner by Agar Magar SN:193779204
- Base Agar Gelosa Sangre by deessire SN:97259412
- PROJECT REPORT ON AViva LIFE INSURANCE by Mayank SN:31375954
- Resep Masakan Indonesia by kokobambang SN:7411103
- Kumpulan Resep Ice Cream by Hany Hady SN:281485925
- Bakso Besar ala Bakso Wonogiri by Cahyo Febri SN:52463934
- Resep es krim by Nur AL-husna D'bit SN:56911216
- Agar XLD by rmarcocarrera SN:60370614
- Resep-masakan by Purnama Pupung Hadi SN:74270183
- Resep ES KRIM SEDERHANA by dicky_naufal SN:48417159
- resep kue.pdf by Widayanti Ishak SN:136374009
- RESEP ES LOLI by allfonso SN:49292868
- Resep Es Oyen Populer Khas Bandung by Aulya Wijayanti SN:155650095
- macam-macam resep dari mamataro.com :D by Azizah Aj Amalia SN:128902629
- Kliping Resep Resep Makanan dan Minuman by Abdul Malik SN:53007910
- agar agar by rahmachan SN:242164515
- SEJARAH KULINER BETAWI by Nike Nurjannah SN:132409217
- Penulisan Resep by Yohan Rush Sykes SN:144273405
- Document by Jaziel Ah SN:54749721
Arsip Blog
-
▼
2019
(1577)
-
▼
January
(534)
- Contoh Makalah Jaringan Sel Pada Tumbuhan
- Daftar Download Game Kelas Memasak Sara For Android
- Koleksi Resep Kue Bolu Gulung Enak
- Kumpulan Cara Buka Usaha Counter
- Contoh Artikel Kiat Sukses Pengusaha
- Daftar Kiatisuk Senamuang Persib
- Download Kumpulan Soal Bahasa Inggris Kelas 1 Smp ...
- Contoh Teori Pendidikan Sistematis
- Download Kiat Bisnis Usaha Kecil
- Contoh Contoh Laporan Keuangan Manufaktur 2010
- Kumpulan Tips On How To Get Rich In Ragnarok
- Contoh Judul Metode Penelitian Manajemen Pemasaran
- Download Masakan Keluarga Praktis
- Kumpulan Masak Ceker Semur
- Download Cara Daftar Sbmptn Di Unesa
- Koleksi Resep Udang Wijen
- Daftar Resep Kue Combro Singkong
- Download Tips For Android Phones
- Contoh Contoh Laporan Perjalanan Dinas Keluar Daerah
- Download Pengertian Dan Cara Sholat Istikhoroh
- Daftar Tips Trik Andromax U
- Daftar Manfaat Nasi Jagung Untuk Diet
- Koleksi Format Cover Tugas Akhir Its
- Contoh Udang Masak Pedas Manis
- Contoh Prosedur Teks Membuat Nasi Goreng Dalam Bah...
- Daftar Cara Buat Paspor Bandung
- Kumpulan Contoh Makalah Perkembangan Desain Grafis
- Koleksi Makalah Tentang Banjir Jakarta 2013
- Kumpulan Install Windows 7 Hard Drive
- Kumpulan Trik Bbm Full Service Gratis
- Download Contoh Proposal Bisnis Plan Pancake
- Download Manfaat Yoga Untuk Kesehatan Rohani
- Koleksi Resep Kue Nagasari Hijau
- Download Kiat Sukses Bisnis Bubur Ayam
- Contoh Belajar Bahasa Jawa Keraton Jogja
- Download Contoh Presentasi Sales Manager
- Daftar Contoh Soal Matematika Dasar Beserta Jawaba...
- Daftar Pengertian Well Formed Xml
- Koleksi Manfaat Ikan Lele Untuk Diabetes
- Download Cara Membuat Kerajinan Tangan Bros Jilbab
- Download Contoh Neraca Dan Catatan Atas Laporan Ke...
- Daftar Tips Bermain Coc Untuk Th 6
- Daftar Contoh Teks Eksplanasi Kompleks Tentang Pel...
- Kumpulan Resep Batagor Yg Enak Dan Mudah
- Contoh Contoh Teks Tantangan Kemacetan
- Kumpulan Contoh Soal Kalkulus Limit Fungsi Trigono...
- Contoh Contoh Teks Pembawa Acara Bahasa Madura
- Contoh Resep Masakan Ayam Bakar Penyet
- Koleksi Resep Kue Bangkit Bawang
- Contoh Tutorial Belajar Microsoft Visual Studio 2012
- Contoh Cara Menggunakan Lucky Patcher Game
- Kumpulan Manfaat Bawang Putih Untuk Asam Urat
- Kumpulan Judul Proposal Skripsi Ilmu Administrasi ...
- Contoh Tutorial Merias Alis Dan Mata
- Contoh Pengertian Neraca Pada Bank Syariah
- Contoh Contoh Laporan Keuangan Perusahaan Dagang T...
- Download Masak Sederhana Tapi Lezat
- Contoh Pengertian Abstrak Dan Tokohnya
- Daftar Bandingkan Teori Perubahan Nilai Uang
- Koleksi Belajar Bahasa Inggris Direct Indirect Speech
- Daftar Resep Jasuke.Com
- Daftar Memasak Ceker Ayam Pedas
- Daftar Skripsi Analisis Laporan Kinerja Keuangan
- Kumpulan Ceker Masak Padang
- Contoh Pengertian Obligasi Menurut Uu
- Kumpulan Resep Hunkwe Yang Enak
- Download Makalah Analisis Swot Renstra
- Kumpulan Prosedur Kesehatan Dan Keselamatan Kerja ...
- Download Manfaat Beras Merah Pada Burung Merpati
- Download Metode Ruqyah Menurut Islam
- Kumpulan Contoh Teks Pidato Singkat Sumpah Pemuda
- Contoh Judul Skripsi Mata Kuliah Administrasi Negara
- Kumpulan Trik Edit Video Movie Maker
- Contoh Makalah Lansia Terbaru
- Koleksi Lirik Lagu Daerah Nias
- Daftar Makalah Pemasaran Dalam Bidang Kesehatan
- Download Open Ebook In Android
- Daftar Contoh Soal Jurnal Umum Akuntansi Dan Jawaban
- Koleksi Resep Kue Sarang Semut Gula Merah Kukus
- Download Tips Sukses Budidaya Ayam Bangkok
- Koleksi Cara Meng Gendut Kan Badan
- Contoh Tips Melakukan Oral Sek
- Download Resep Nasi Goreng Ayam Cincang
- Daftar Manfaat Daun Sirih Merah Untuk Penderita Di...
- Koleksi Kelebihan Dan Kelemahan Metode Luff Schoorl
- Daftar Pengertian Komunikasi Melalui Radio
- Daftar Contoh Abstrak Bahasa Jawa
- Download Prosedur Tindakan Vulva Hygiene
- Download Pengertian Bahasa Jawa Krama
- Koleksi Pengertian Hak Lintas Damai Dan Dasar Huku...
- Download Skripsi Produk Bank Syariah
- Daftar Tips Fashion Betis Besar
- Kumpulan Kliping Tentang Hari Pahlawan
- Kumpulan Perbedaan Metode Jigsaw Dan Ceramah
- Koleksi Belajar Mobil Kediri
- Daftar Manfaat Jus Alpukat Dicampur Madu
- Kumpulan Contoh Surat Pajak Barang Mewah
- Koleksi Resep Udang Pedas Mnis
- Download Contoh Laporan Audit Manajemen Internal
- Koleksi Tutorial Rambut Keriting Bawah
- Koleksi Latar Belakang Makalah Nilai-Nilai Pancasila
- Kumpulan Resep Gulai Ikan Sarden
- Koleksi Metode Penelitian Studi Pustaka
- Contoh Belajar Bahasa Inggris Lengkap Gratis
- Contoh Kumpulan Soal Dan Pembahasan Matematika Bab...
- Contoh Video Membuat Kue Lupis
- Koleksi Resep Kue Singkong Dikukus
- Download Resep Es Campur Agar Agar
- Daftar Resep Umpan Ikan Mas Paling Jitu
- Koleksi Resep Cheese Cake Catatan Nina
- Kumpulan Resep Pizza Lembut
- Kumpulan Tutorial Ombre
- Koleksi Cara Membuat Laporan Penelitian Sosiologi
- Kumpulan Tutorial Jilbab Untuk Kebaya Sederhana
- Daftar Skripsi Hubungan Antara Motivasi Belajar De...
- Download Contoh Soal Bentuk Akar Dan Jawabannya
- Kumpulan Contoh Laporan Audit Manajemen Internal
- Kumpulan Ebook Kozier And Erb'S Fundamentals Of Nu...
- Download Kliping Tentang Renang 30 Lembar
- Kumpulan Artikel Hewan Beserta Ciri Cirinya
- Contoh Arti Ungkapan Guru Kencing Berdiri Murid Ke...
- Download Vidio Tutorial Hijab Untuk Ke Pesta
- Download Tips For Garage Gym
- Daftar Contoh Soal Integral Luas Daerah Bidang Datar
- Kumpulan Contoh Announcement Text About Competition
- Kumpulan Resep Nasi Uduk Jogja
- Daftar Ebook Belajar Excel 2007
- Kumpulan Teori Ekonomi Klasik Pasar Barang
-
▼
January
(534)
Powered by Blogger.
Mengenai Saya
Friday, January 25, 2019
Download Resep Es Campur Agar Agar
Subscribe to:
Post Comments (Atom)
Cari Blog Ini
-
KORELASI CONTOH SOAL by Sevenfold Shop SN:173548564 MULTIVARIAT -Analisis Korelasi Kanonik b...
-
Metode Penelitian DR. Sugiyono by Aries Triwibowo SN:47534832 DAFTAR PUSTAKA (Jngn Dipindah ...
-
belajar fotografi by jiwamerapuh SN:45842863 Tips Fotografi Sederhana by Dhannie Setiawan SN...

No comments:
Post a Comment